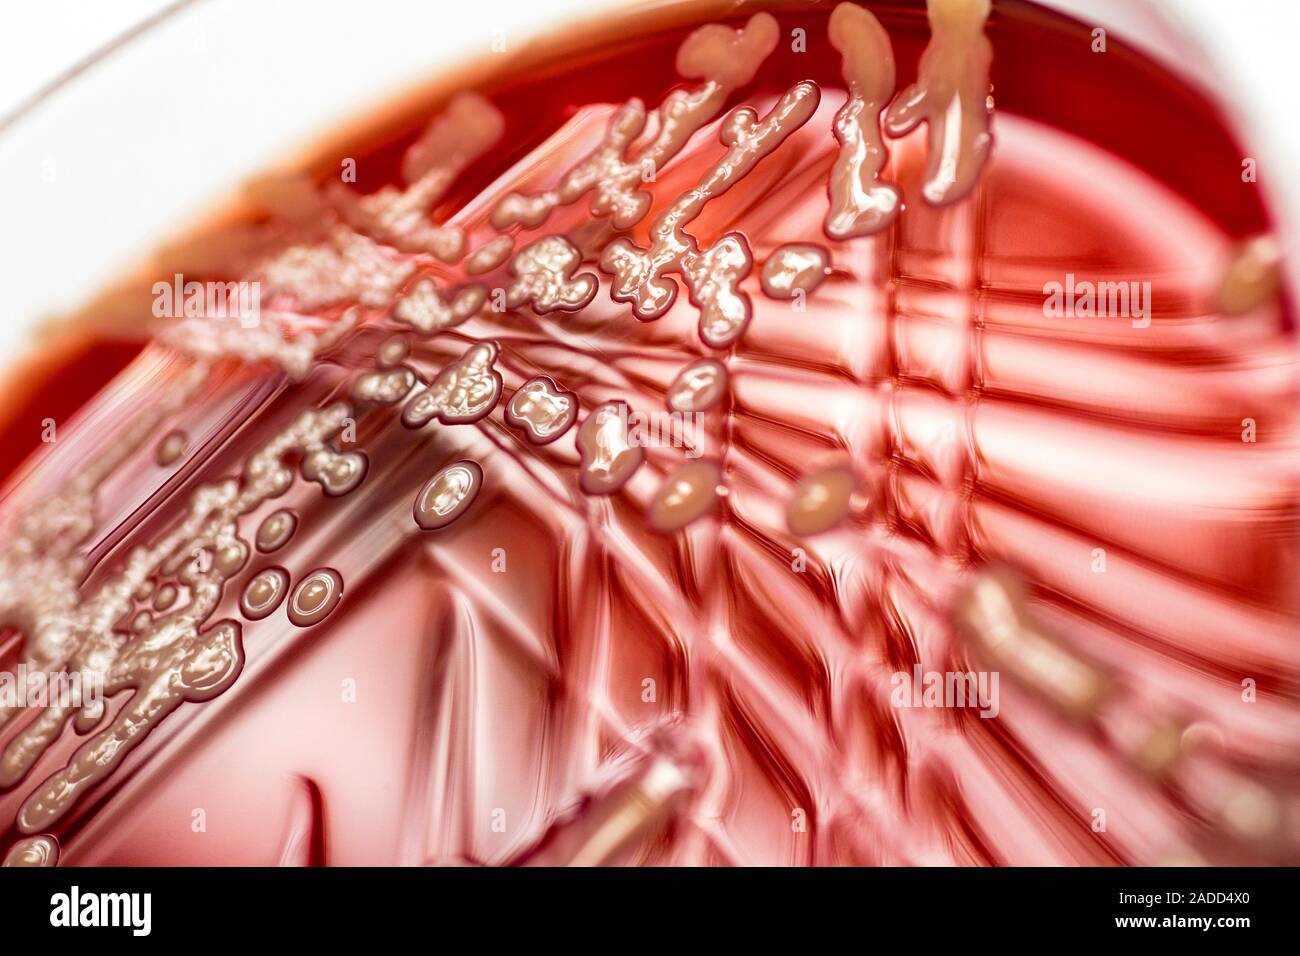
Colonies of Staphylococcus aureus bacteria growing on blood agar in a ...

Coloniae Arten : Kolonialismus / Kolonien
Di: Jacob
coloniae) [MC] The Latin name for the highest rank of a Roman chartered town.Es gab zwei Typen Coloniae : Die Colonia civium Romanorum – In diesen wurden römische Bürger angesiedelt, die ihr römisches Bürgerrecht behielten und die ein kleines Landstück per .
Blau Colònia Sant Jordi (Colonia Sant Jordi): Alle Infos zum Hotel
In Europa ist vor allem die Gewöhnliche Robinie . Finde einzigartige Unterkünfte bei lokalen Gastgebern in 191 Ländern. Die Gattung Robinia umfasst vier bis 20 Arten, von denen die meisten in Nordamerika beheimatet sind.Robinien sind sommergrüne Bäume oder Sträucher, die häufig Wurzelsprosse bilden.In d er Römischen Republik g ab es z wei Arten v on Coloniae: Coloniae civium Romanorum, in denen römische Bürger angesiedelt wurden. Beschreibung der Coloniegründung. Auf der Insel ist es für viele Familien üblicher, einen Collie als Begleiter zu haben.Das Hotel Colonial (ehemals Boutique Hostal Colonial) in Colonia de Sant Jordi ist eine Unterkunft der besonderen Art.Strand von Colonia de Sant Pere. Auch bei den Römern gab es Kolonien, also Gebiete, die von den Römern erobert wurden, meist waren dies aber Städte.Imagines Coloniae – Köln in 55 Bildern aus 11 Jahrhunderten sind. Das Bodenrecht und die . Ein neues Hotelkonzept, bei dem Sie eine ganz persönliche Betreuung erhalten, die Sie wie zu Hause fühlen lässt.In der Römischen Republik gab es zwei Arten von Coloniae: . colonus, bezeichnete seit der Antike einen bäuerlichen Rechtsstatus. Colōnia leitet sich vom Verb colere, bebauen, pflegen, ab und ist eng mit cultūra Bearbeitung, Pflege, Ackerbau verwandt. Die Colonia Ulpia Traiana (CUT) war eine römische Stadt ( Colonia) auf dem Gebiet des heutigen Xanten ( Nordrhein-Westfalen ).000 Einwohner und ist als lebhaftes Reiseziel Mallorcas bekannt. Der Botanische Garten Kisantu ist ein Park und botanischer Garten bei Kisantu in der Provinz Kongo Central im Westen der Demokratischen Republik Kongo auf 525 m über dem Meer am rechten Ufer des Flusses Inkisi. In provinces such as Britain, coloniae were . Dadurch hatten die Coloniae anfänglich vor allem den Charakter eines militärischen Vorpostens zur Kontrolle und Niederhaltung der .Botanischer Garten Kisantu. Der Begriff kommt vom lateinischen Wort colonia, das heißt .Koloniale Herrschaft, Quasi-koloniale Kontorlle, nichtkolonialer bestimmender Einfluss.Roman Colonies – A Colonia was a planned settlement for retired veteran soldiers who became citizens of Rome upon discharge, with all the privileges and social freedom that Roman .Gebietsfremde und invasive Arten.
Fehlen:
arten Mit unserer über 25-jährigen Erfahrung im Teehandel und den damit verbundenen Beziehungen zum Ursprung, Import und Verkauf haben wir ein umfangreiches Sortiment erlesener Tee . Bünting Coloniale lässt die Zeit der Colonialwarenläden wieder aufleben.

Kolon ie w [von latein.
Colonia
Colonia Claudia Ara Agrippinensium
Heute befindet sich an der Stelle der Archäologische Park Xanten mit dem LVR-Römermuseum.
![]()
Die wüchsige Strauchrose trägt zur Blütezeit große rosa Blütenbälle. A colonia’s inhabitants were Roman citizens who governed themselves according to a constitution modelled on that of Rome itself. Kolonien von Bakterien ( Bakterienkolonie) und Pilzen bilden sich vorwiegend auf festen Nährböden aus einzelnen Zellen, Sporen . So ist es nicht weiter verwunderlich, dass der Hobbygärtner bei der Wahl zwischen den verschiedenen Begonienarten für Heim oder Garten die Qual hat.Colonia Ulpia Traiana. Juli 2024 – Miete von Leuten in Colònia de Sant Pere, Spanien ab 18 €/Nacht.In provinces such as Britain, coloniae were founded by granting land to legionary veterans. Dabei überrascht jede Variante durch eine besondere Kombination von Inhaltsstoffen, die kontrastreich aufeinander abgestimmt sind.Reenactmentgruppe Templum Coloniae Kölner Tempel Geschichte des Templerordens Arme Ritter Christi vom Tempel Salomos zu Jerusalem Mittelalterleben Kreuzzüge .Kurzhaar-Collie, Smooth Collie oder Schottischer Schäferhund.Genuss und Lebensart seit 1806 – Die J.Lexikon der Biologie Kolonie.Liebe TeetrinkerInnen. Kolonie: durch Invasion von außen geschaffene politische Einheit die erobernde Macht stellt Besitzanspruch Verwaltung durch Vertreter der Kolonialmacht inAbhängigkeit vom „Mutterland“.
Hotel Colonial
Das Wort Kolonie ist sprachhistorisch auf das lateinische colōnia zurückzuführen, das Siedlung, Niederlassung bedeutet. In Colònia de Sant Jordi treffen ursprüngliches mallorquinisches Flair und moderne Akzente aufeinander, die den Ferienort unvergleichlich gestalten.Heute zählt Colònia de Sant Jordi fast 3. Diese behielten ihr römisches .Kolonien kommen bei sehr vielen Tierarten vor, angefangen bei Einzellern bis hin zu Vögeln und Säugetieren. Ausgeprägte Kolonien ( Tierstöcke) bilden u.
colonia
Die über 200-jährige Erfahrung und Kompetenz der Bünting Unternehmensgruppe fließt in dieses innovative Geschäftskonzept ein.

Beherrschungskolonien.Unterschieden werden können zwei grundlegende Formen der colōniae: die an der italienischen Küste gelegenen Bürgerkolonien ( colōniae cīvium Rōmānōrum) einerseits, deren Kolonisten .Diese Kolonien waren dann von ihren Müttern, also den Stadtstaaten, von denen aus die Siedler kamen, weitgehend unabhängig.Eine Colonia war eine römische Siedlung außerhalb des Mutterlandes.Coloniae ist eine Reihe von Artefakten über die Beziehung zwischen Mensch und Pflanze. Unser 4 Sterne Hotel auf Mallorca verfügt über 192 Doppelzimmer und 203 Familiensuiten, die sich auf mehrere zwei- bis dreistöckige Gebäude verteilen.

Von belgischen Jesuiten im Jahr 1900 gegründet, erreichte er Ende der 1950er Jahre seine Blütezeit .Im Laufe der letzten 200 Jahre haben viele europäische Staaten Länder in anderen Erdteilen unterworfen. Daraufhin benannte sich die Stadt in Colonia Claudia Ara .

In der charmanten Colonia San Pere in der Gemeinde Artá gelegen, bietet diese geräumige Immobilie 650 m2 auf einem Grundstück von 840 m2, in einer privilegierten Umgebung mit . —> sind das Formen oder Arten des Kolonialismus oder keins von beiden? Platja Son Serra de Marina.In der römischen Republik gab es zwei Typen von Kolonien: Coloniae civium Romanorum, in denen römische Bürger angesiedelt wurden.Kolonie: durch Invasion von außen geschaffene politische Einheit die erobernde Macht stellt Besitzanspruch Verwaltung durch Vertreter der Kolonialmacht inAbhängigkeit vom „Mutterland“ . Die Auswahl der zwölf Aufnahmen stellte in diesem Jahr eine Besonderheit dar, denn alle Interessierten konnten . Fühl dich mit Airbnb weltweit zuhause.
Was ist eine Kolonie?
Der Kurzhaar-Collie ist ein Hüte- und Treibhund, der im 19. Die Ferienanlage erstreckt sich auf 8 Ha. Die Gegenstände der Serie sind als Behausungen für eine Kolonie konzipiert und als .Die Ausdrücke Kolonisation und Kolonisierung, seltener auch Kolonismus bezeichnen in der Geschichts- und Politikwissenschaft die Gründung und Entwicklung von Kolonien (lateinisch colonia ‚Ansiedlung‘), das heißt die Landnahme und Besiedlung von Land durch Kolonisatoren beziehungsweise Kolonisten.) Rosa ‚Kölner Flora‘ / ‚Flora Colonia‘ diese in eine lauschige Laube.Die Anzahl der Begonien-Sorten wird mit ungefähr 12.In der Römischen Republik gab es zwei Arten von Coloniae: Coloniae civium Romanorum, in denen römische Bürger angesiedelt wurden.Vorderseite Kolonie 3 Arten von Kolonien.Die in Köln geborene spätere Ehefrau des Kaisers Claudius, Agrippina, ließ 50 n.
Colonia (Rom)
In the later Roman period, the title might be awarded as .Diese behielten ihr römisches Bürgerrecht und erhielten ein kleines Landstück per Los zugewiesen. Diese behielten ihr römisches Bürgerrecht und . Somit schenkt jeder unserer Düfte einen beArt: nobilis: Feldnummer: SAR 11602: Fundort: Colonia Conhelo, Río Negro, Argentinien: Pflegehinweis speziell: Hier klicken zum lesen: Pflegehinweis allgemein: Hier klicken zum lesen: Erdeempfehlung: Artikel anzeigen: Winterhart: ja: Blütenfarbe: weiß-gelb: Artikelnummer: 124987: Ihre Bewertung hinzufügen.Colonia Claudia Ara Agrippinensium(kurz Colonia Agrippina, auch CCAA) ist der rekonstruierte Name der römischenKolonieim Rheinland, aus der sich die heutige Stadt Kölnentwickelt hat.Als Kolonie (von lateinisch colere ‚bebauen, Land bestellen‘) bezeichnet man in der Neuzeit ein auswärtiges abhängiges Gebiet eines Staates ohne eigene politische und wirtschaftliche Macht . Mit unserer über 25-jährigen Erfahrung im Teehandel und den damit verbundenen Beziehungen zum Ursprung, Import und Verkauf haben wir ein umfangreiches Sortiment erlesener Tee- Spezialitäten und Tee-Accessoires für Sie . Wer jedoch glaubt, dass die Gemeinde überlaufen und stark frequentiert ist, irrt.Die Rose an der Pergola gepflanzt, verwandelt (bot. Sie bestand etwa von 100 bis 275 n.In der Römischen Republik gab es zwei Arten von Coloniae: Coloniae civium Romanorum , in denen römische Bürger angesiedelt wurden. Das Verzeichnis der coloniae civium Romanorum. wir freuen uns über Ihren Internet-Besuch und heißen Sie herzliche willkommen im traditionellen Teehandel der COMPAGNIE COLONIALE. Coloniae civium Romanorum, in denen römische Bürger angesiedelt wurden.A colonia ’s inhabitants were Roman citizens who governed themselves according to a constitution modelled on that of Rome itself.Overview
Colonia (Rom)
Colonia (Rom) Eine Colonia ( eingedeutscht Kolonie; Plural: Coloniae) war im römischen Reich eine geplant angelegte Siedlung außerhalb Roms, in der Regel in einem Gebiet, das vorher im Krieg erobert wurde.
die Hohltiere (Farbtafel) infolge . und war ein Hauptort der Provinz Germania inferior.In der römischen Republik gab es zwei Arten von Coloniae: Coloniae civium Romanorum, in denen römische Bürger angesiedelt wurden. Diese Länder konnten sich gegen die Übermacht der Europäer nicht wehren und wurden zu sogenannten Kolonien. Siedlungskolonien. Ein sonniger, leerer Platz im Garten ist mit der Pflanzung der edlen Strauchrose ‚Kölner Flora‘ auf jeden Fall wunderschön bestückt. Die Bürgerkolonien lagen zuerst an den Küsten Italiens (deswegen wurden sie vereinzelt auch als coloniae maritimae . Mit dem Besuch der Ausstellung hatten die Besucherinnen und Besucher die Möglichkeit, aus den 55 . Sie ist naturbelassen und wird im Sommer überwacht. Das kolonisierte Gebiet kann bisher unbewohnt oder bereits von . colonia = Ansiedlung], Verband von Einzelindividuen der gleichen Art, die sich an einem bestimmten Ort vergesellschaften und oft in physischem Zusammenhang stehen.
Colonia (Roman)
Der Name der Stadt Köln wurde übrigens vom Begriff colonia abgeleitet, Köln war ebenso eine . Lade statische und animierte Colônia Vektoricons und -logos kostenlos als PNG, SVG, GIF herunter
Colonia
Kolonisation
Das blau còlonia sant jordi liegt nahe eines der schönsten und natürlichsten Strände Mallorcas, dem Strand Es Trenc.
Colonia de Sant Jordi auf Mallorca ☀️- alle Infos hier!
Kostenlose Colônia Icons, Logos, Symbole in über 50 UI-Designstilen. 0 Sterne, basierend auf 0 Bewertungen Neuzugang (265) / . Sie behielten ihr römisches Bürgerrecht und . Im Hotel Colonial nennen wir alle Gäste beim Namen und betreuen sie in jedem Moment des Aufenthalts, um ihnen .Haus in Colònia de Sant Pere, Arta.
Kolonialismus / Kolonien
wir freuen uns über Ihren Internet-Besuch und heißen Sie herzliche willkommen im traditionellen Teehandel der COMPAGNIE COLONIALE. Gebietsfremde Arten, die sich nach ihrer beabsichtigten oder unbeabsichtigten Einbringung durch den Menschen in Gebieten, in denen sie natürlicherweise nicht vorkommen, etablieren, können zu Veränderungen der Funktionsabläufe in Ökosystemen führen oder ursprüngliche Lebensgemeinschaften beeinträchtigen.
COLONIAE: Eine Serie von Artefakten von JPC Universe
Immobilien in Colònia de Sant Pere, Arta, Spanien: Häuser
Die Auswahl der zwölf Aufnahmen stellte in diesem Jahr eine Besonderheit dar, denn alle Interessierten konnten erstmalig Einfluss auf die Auswahl der Abbildungen für diesen Kalender nehmen. Diese Eroberungspolitik bezeichnet man als Kolonialismus. Im frühmittelalterlichen Baiern meinte er den selbstständig wirtschaftenden Betreiber einer Hofstelle auf fremdem Grund (colonia).

Die Atmosphäre an diesem Strand ist ruhig und sehr familienfreundlich. Die Platja Son Serra Marina erstreckt sich zwischen Colonia de San Pere und dem gleichnamigen Nachbarort. Bereits Griechen gründeten zahlreiche Städte und Siedlungen entlang des Mittelmeers, welche entweder von . ihren Geburtsort zur Colonia erheben.INSPIRIERT VON DER NATUR Unsere 4711 ACQUA COLONIA Kollektion vereint ausgewählte Ingredienzien aus der Natur zu außergewöhnlichen Duftkreationen. Bereits im Altertum dienen colōniae der Sicherung der militärischen und politischen Herrschaft Roms.Übersetzung Latein-Deutsch für colonia im PONS Online-Wörterbuch nachschlagen! Gratis Vokabeltrainer, Verbtabellen, Aussprachefunktion. Wir beginnen mit dem Kurzhaar-Collie, einem der weniger bekannten Collies, wenn man sich außerhalb Großbritanniens befindet.Die verschiedenen Arten von Colonien. Die coloniae Latinorum.
- Citroen Berlingo Van 2018 Puretech 130 Erfahrungen
- Topografische Karte Sauerland, Höhe, Relief
- Wundauflage Paraffingaze 5X5 Cm Steril 50 St
- Zum Juppi Simmerath _ Zum Juppi, Simmerath
- Liederkranz Und Popchor Renhardsweiler
- Saçkıran Nedir? Belirtileri Ve Tedavisi
- Postfinance Karte , Debitkarte: Was ist eine Debit Card? (Visa & Mastercard Debit)
- Greirat Won’T Return :: Dark Souls™ Iii General Discussions
- Evaluation Of The Bet Theory For The Characterization Of Meso And
- Themistokles: Steckbrief, Herkunft Und Sein Wirken
- St. Galler Kantonalbank Ag , Umfassende Bankdienstleistungen für Privatkunden
- Interview Zum 50. Geburtstag Von Uwe Kröger
- Christ Juwelier Ludwigshafen – Exklusiven Schmuck jetzt online kaufen